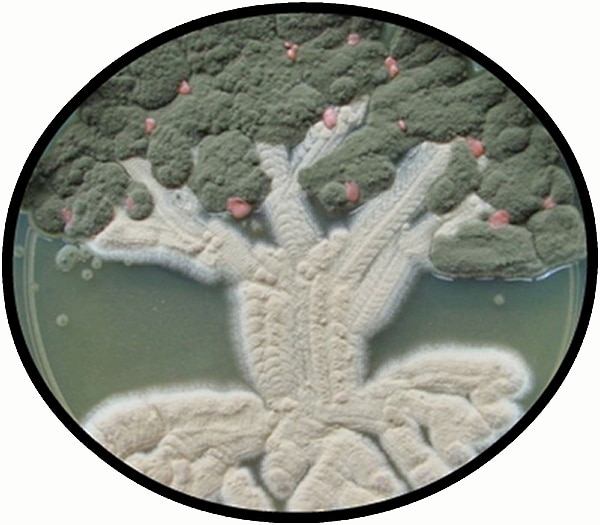
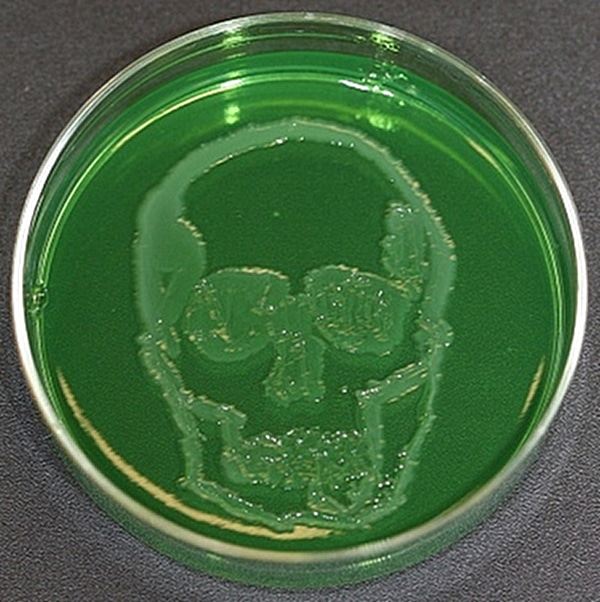

You are either going to feel dirty and rush to wash your hands after reading this, or you are going to think it’s kinda neat. I fall somewhere in the middle. The inside of a human body is truly fascinating, and it gets even more mysterious and interesting when put under a microscope. Whether you are looking at brain cells, plaque on a tooth or just about any other biological microbe, it’s really entertaining in a bizarrely beautiful way.
What about germs and bacteria? One thing I’ve never seen until today are creative people who make art from living things usually only found in a Petri dish in a science lab somewhere. It’s called Microbial Art, and it’s created using living bacteria, fungi and protists.
It’s where science and art meet, in a germy kind of way. I would think this type of art requires the ultimate patience. Not only do the artists have to wait until just the right moment to create the artwork itself, but the drawings also change as the bacteria grow and die. In addition, many times the photographs have to be taken in perfect lighting conditions (or in complete darkness) since many forms of bacteria are super sensitive to light. In other words, the stars and the universe have to align perfectly to a make this all work out just right, and my guess is, that is part of the appeal for these microbial artists.
In the video below, artist Hunter Cole even created a drawing from her own DNA. You can click over to this article on Flavorwire to get more information about each one of the artists who created the designs below, and which form of bacteria they used.
This one shows the effects of photosynthesis.

This last one was created by Alexander Fleming, the man who created Penicillin in 1928.

Via: [neatorama]

COMMENTS